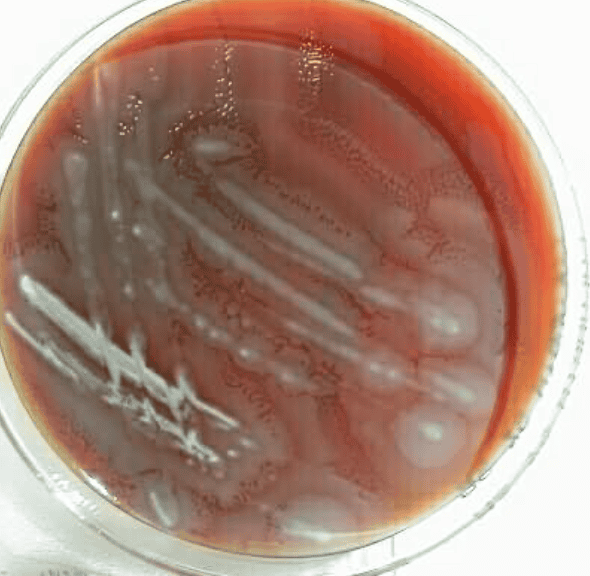

Фотографии бактерии Протеус мирабилис и её особенностей






















































.jpg)

Раздел: Другие животные